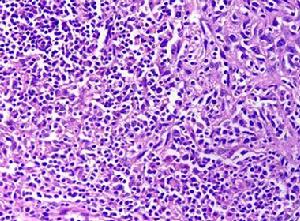
（圖）癌細胞

面部基底細胞癌
面部基底細胞癌基底細胞癌是皮膚癌最常見類型之一,好發於頭面部位,多見於戶外工作者和老年人。本病由Jacob於1827年首先描述但到1902年才由Krompecher將其與其他上皮性腫瘤明確區分。其特點是發展緩慢,呈浸潤性生長,但很少有血行或淋巴道轉移。
流行病學
國外基底細胞癌占皮膚癌的50%~65%,中國皮膚癌中以鱗癌多見,與基底細胞癌的比例為5∶1~10∶1。
病因
基底細胞癌源於皮膚或附屬檔案尤其是毛囊的基底細胞,是一種低度惡性腫瘤。
發病機制
基底細胞癌起源於表面或皮膚附屬檔案的多能性基底樣細胞,可分多方向分化。癌細胞似基底細胞呈卵圓形或梭形胞核染色深,胞質少胞界不清楚。瘤實質與間質之間有對PAS染色呈陽性反應的基底帶。間質結締組織內成纖維細胞增生。間質因含大量酸性黏多糖而呈黏液樣,當標本經固定脫水後,間質內黏蛋白皺縮導致部分或全部與瘤實質分離。但通過這種現象在病理學上與鱗癌等腫瘤相區分。
臨床表現
 症狀
症狀基底細胞癌早期表現為局部皮膚略呈隆起、淡黃色或粉紅色小結節,僅有針頭或綠豆大小,呈半透明結節質硬表皮菲薄,伴有毛細血管擴張但無疼痛或壓痛。病變位於表皮深層者,表麵皮膚略凹陷失去正常皮膚的光澤和紋理,經數月或數年後,表現出現鱗片狀脫屑,以後反覆結痂脫屑,表現潰爛、滲血。當病灶繼續增大時,中間形成淺表潰瘍,其邊緣參差不齊,似蟲蝕樣。表面形成多種多樣,大致可分為以下幾種類型:
1.結節潰瘍型 較常見,損害為單個,自針頭大小至綠豆大小,呈半透明結節質硬表面菲薄,伴毛細血管擴張稍受外傷即出血。其後漸增大中央凹陷,表面糜爛或潰破,潰瘍底部呈顆粒狀或肉芽狀菜花樣,覆以漿液性的分泌物;邊緣繼續擴大,可見多數淺灰色呈珍珠樣外觀的小結節,參差不齊向內捲起。這是此癌典型的臨床形態,稱之為侵蝕性潰瘍。
2.淺表型 少見。多見於男性,發病年齡較早,頭部極少。
3.局部性硬化型 極少見,好發於面部、額部、顴部、鼻部和眼眥等處。損害為單發,表現為扁平或稍隆起的浸潤塊,呈不規則或葡行狀,大小自數毫米至占據整個前額部,灰白至淡黃色,表面光滑,可透見毛細血管擴張。生長緩慢,觸之較硬,多有破潰,類似局限性硬皮病。
4.瘢痕性癌 罕見多發生於面部,損害為淺表性結節狀斑塊,生長緩慢。
5.色素化基底細胞癌 是以上各型中出現色素沉著者。
診斷
當基底細胞癌有典型特徵時,如結節超過數毫米時容易識別,可根據臨床表現做出診斷。
鑑別診斷:
早期色素增加的基底細胞癌與傳染性軟疣老年性皮腺增生則難區別後者可見在損害中央有充以角蛋白的點狀凹陷。當基底細胞癌表面有明顯結痂或鱗屑時,應與尋常疣、角化棘皮瘤和鱗癌等相鑑別。而色素性基底細胞癌,可被誤診為黑色素瘤。基底細胞癌邊緣內卷,有毛細血管擴張,色澤呈褐色,周圍無色素暈。淺表型基底細胞癌則頗似濕疹、扁平苔蘚銀屑病,但要注意其線形邊緣不清楚,可與局限性硬皮病相鑑別。但最終往往靠病理檢查來確定。
治療
癌細胞
癌細胞基底細胞癌對放射線敏感,一般採用放射治療。
1.放射療法 劑量與照射範圍視病灶大小而定:凡病灶直徑<1cm,較表淺的,可採用50kV接觸治療,總劑量22Gy;病灶直徑<5cm,厚度<0.5cm者用120~140kV中度X線分割治療療程2~3周或3~5周;病灶直徑>5cm,浸潤較深者用160~180kV分割治療,療程3~5周總劑量45~60Gy。放射治療的優點是療效佳,頭面部不留瘢痕。但對局部硬皮病樣基底細胞癌則不適用。
2.化學治療 凡無淋巴轉移者,頭面部基底細胞癌一般不主張全身性化療,多套用局部搽敷抗癌藥。
(1)1%~5% 5-氯尿嘧啶軟膏塗抹早晚各1次,持續2~3周局部可能發生糜爛,改用抗生素油膏塗擦。
(2)20%贍酥軟膏,皮癌淨全身用平陽毒素15mg1次/d,總劑量600~900mg對較大病灶則局部用藥療效應慎用。
3.冷凍治療 適用於富於纖維成分,病灶不大的基底細胞癌。以病灶中心及周圍2~5cm正常組織作為治療區域,用液氮噴射到癌中央,一般持續30s左右,使局部溫度降到-20℃,然後緩慢解凍。如無精確溫度計測試臨床上可按停止使用液氮後到解凍需要的時間來粗略估計冷凍是否足夠。一般頭頸面、面部的小病灶至少1.5min,還常需重複進行,解凍2次第二次可據第一次治療程度作適當調整。當腫瘤組織壞死脫落後用生理鹽水沖洗,並塗以抗生素油膏, 2次/d,3~4周傷口可完全癒合。據報導冷凍治療後,頭皮基底癌復發率高,故多認為不宜採用。
4.雷射治療 常用CO2雷射及Nd:YAG。用高能量切割低能量凝固,適用較淺表腫瘤,優點是損傷小,修復好,缺點是缺乏邊緣組織病理檢查。
5.手術治療 對病灶>1cm者手術仍是主要療法,必要時可結合放療聯合套用。
(1)刮除手術:適用於淺表、較小的基底細胞癌。在局麻下先用3~4mm大小刮匙刮除周邊和基底殘餘瘤組織,最好用電凝燒灼傷口塗以抗生素油膏,優點是傷口小。適用於面部和額部。
(2)化學外科:美國醫師Mohs首創,原先用氯化鋅糊劑固定腫瘤後,將其水平削下送病理檢查,每削一次送檢一次,直至送檢組織無癌組織為止。目前已無需用氯化鋅糊劑,直接水平方向切削新鮮組織。此法適用於較大腫瘤,治癒率達99%其技術難度較大。有人認為此法與手術切除送冷凍切片檢查,並無本質區別。
(3)手術切除:根據灶大小,有無轉移來決定切口範圍和操作深度。當腫瘤深入顱骨時,應將累及的顱骨甚至硬腦膜一併切除,再做修復與植皮手術。
預後
基底細胞癌生長緩慢很少發生淋巴結節轉移,預後較好。
